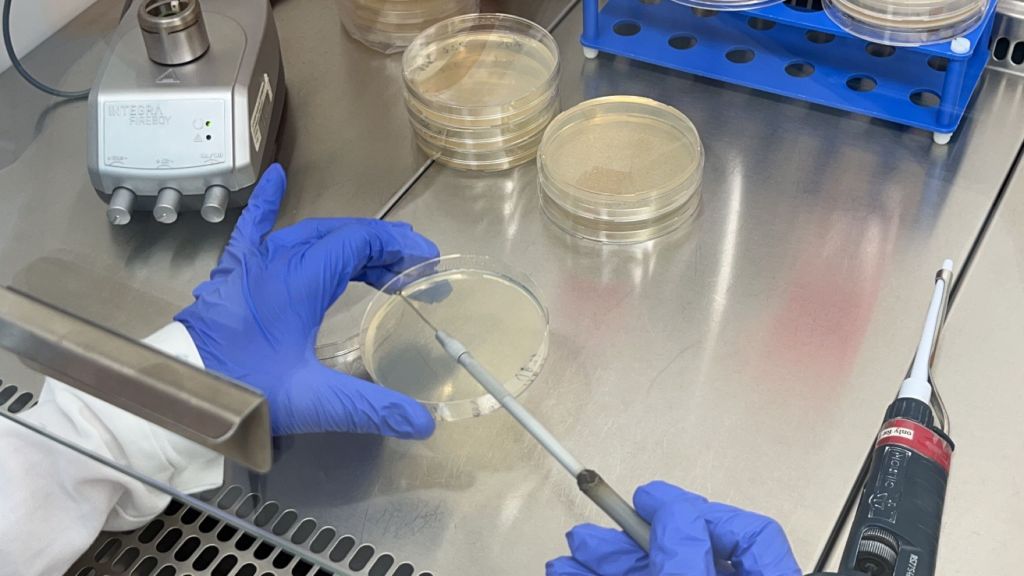

Im Zuge unseres 14-wöchigen Praktikums, absolvierten wir (Sophia und Tobias) 4 Wochen in Mondsee. Wir konnten Einblicke in das Arbeitsleben einer Forschungsgruppe gewinnen und sahen was mit unseren Wasserproben vom Workshop passierte.
Uns war es möglich selbstständig Arbeit zu erledigen und somit konnten wir vieles dazulernen und festigen. Zu unseren Tätigkeiten gehörten Arbeiten im Labor, wie Verdünnungsausstriche und das Überimpfen von Kulturen, als auch digitale Sequenzen mit bekannten Arten zu Vergleichen. Wir haben auch bei mehreren Workshops geholfen und sind mit dem Team an verschiedene Orte gefahren, um Proben zu nehmen.
Durch die spannende Arbeit und das lustige Team, hatten wir ein tolles Praktikum an dem Limnologischen Institut Mondsee der Universität Innsbruck.